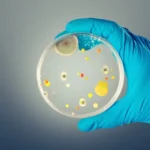
Aeroporto Santos Dumont, no RJ, é fechado após vazamento de óleo na pista

(FOLHAPRESS) – O aeroporto Santos Dumont, no centro do Rio de Janeiro, foi fechado para pousos e decolagens na manhã desta terça-feira (30) após um vazamento de óleo na pista. Voos foram cancelados e atrasados no início da manhã desta terça.
Segundo o aeroporto, um veículo que trafegava fazendo a inspeção durante a noite acabou derramando óleo na pista
O vazamento aconteceu próximo à cabeceira da pista, local onde as aeronaves tocam o solo durante o pouso e quando fazem a aceleração final durante a decolagem.
Por volta das 7h50, equipes ainda faziam a limpeza no local. De acordo com informações do aeroporto, as operações ficarão paralisadas até a conclusão dos trabalhos, o que deve ocorrer ainda pela manhã.